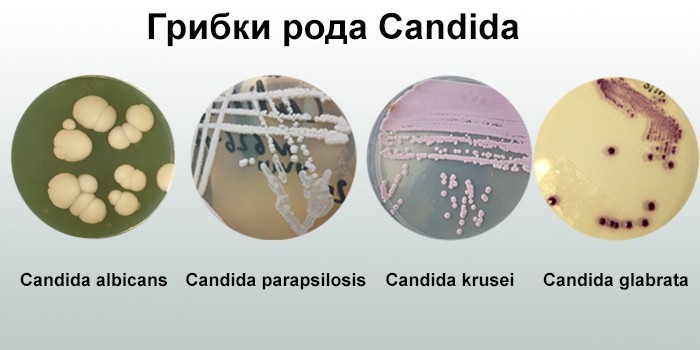
image

По статистике, более 2/3 людей в мире хотя бы раз сталкивались с кандидозом. Его синонимическое название – молочница. Это воспалительное грибковое заболевание слизистых оболочек или кожных покровов, вызванное размножением патогенных микроорганизмов рода Candida.
Причины молочницы
Грибок Кандида (Candida) относится к семейству несовершенных дрожжеподобных микроорганизмов. Он имеет овальную либо круглую форму и образует псевдомицелий (удлиненные нити из клеток), бластоспоры (клеточные почки) и хламидоспоры (споры с двойной оболочкой).
Грибки присутствуют в окружающей среде, в некоторых продуктах питания (квас, сладости, пиво), ротовой полости, влагалище и кишечнике здорового человека. Наука насчитывает более 100 видов Кандида, но опасными для человека являются только некоторые из них:
- альбиканс (Candida albicans);
- тропикалис (parapsilosis);
- крузеи (krusei);
- глабрата (glabrata).
В норме их количество в организме минимальное и регулируется другими представителями микрофлоры и иммунитетом человека. Начало воспалительного кандидозного процесса провоцируют такие факторы:
- гормональный дисбаланс;
- дисбактериоз кишечника из-за длительного приема антибиотиков;
- нарушение целостности кожных покровов или слизистых (раны, ожоги, потертости);
- хронические заболевания пищеварительного тракта – синдром раздраженного кишечника, язва, атрофический гастрит, энтероколит;
- сахарный диабет;
- онкологические болезни;
- вирус иммунодефицита человека (ВИЧ);
- тяжелая аллергия;
- ношение синтетического белья;
- нервный срыв;
- венерические заболевания;
- неправильное питание – преобладание в меню углеводной пищи;
- детский либо пожилой возраст;
- снижение иммунитета.

Мнение врачей:
Кандидоз вызывается грибком Candida, который может поражать различные части тела. У женщин чаще всего поражаются влагалище и влагалищные губы, у мужчин – половой член, а у детей – ротовая полость и памперсная область. Симптомы кандидоза включают зуд, жжение, выделения, покраснение и отечность. Лечение зависит от места поражения: для женщин используются противогрибковые мази и свечи, для мужчин – антимикотики в виде кремов или таблеток, для детей – местное лечение и противогрибковые препараты. Важно обратиться к врачу для точного диагноза и назначения эффективного лечения.

Как передается Кандида
Источник инфицирования Candida spp. – собственная микрофлора. При снижении иммунитета или на фоне других благоприятных факторов грибок активно размножается, замещает часть полезной флоры. Заражение микроорганизмами извне возможно по таким причинам:
- незащищенный половой акт;
- оральные ласки гениталий;
- заражение ребенка во время беременности и родов, если мать болеет кандидозом;
- длительное пребывание в воде (грибок любит влажную и теплую среду);
- повреждение кожи либо ногтевой пластины маникюрными инструментами;
- контакт с инфицированными домашними животными – щенками, телятами, жеребятами.
Виды молочницы
Классификация кандидоза разнообразна. Определить тип заболевания может врач, основываясь на результатах диагностики. В зависимости от тяжести протекания, выделяются такие формы молочницы:
- Кандидоносительство. Симптомы болезни отсутствуют, но зараженный человек может инфицировать окружающих.
- Острая форма. Симптомы возникают внезапно и сильно беспокоят пациента. Продолжительность заболевания 1–2 месяца.
- Хроническая– осложненная молочница, вызванная атипичными возбудителями. Протекает малосимптомно. Длится больше 2 месяцев.
- Персистирующая. Отдельные признаки патологии появляются по нарастающей либо убывающей.
- Рецидивирующая. Для болезни характерны периоды обострений и покоя. Такая форма патологии чаще встречается у женщин, симптомы нарастают перед началом менструации либо во 2 половине цикла.

По характеру распространения инфекции выделяются такие формы кандидоза:
- Поверхностный. Воспалительный процесс поражает гладкую кожу лица, слизистую носа, ладони, ногти на руках и стопах, область промежностей и грудь.
- Висцеральный (системный). Молочница внутренних органов – желудка, пищевода, заднего прохода, глаз.
- Кандидозный сепсис– тяжелая форма системного кандидоза. Грибок с током крови из основного очага переносится к другим органам. Болезнь часто заканчивается смертью.
По локализации грибковой инфекции выделяются такие формы кандидозного заболевания:
- межпальцевая;
- урогенитальная;
- вагинальная;
- кандидомикоз – поражение кожных покровов;
- онихомикоз – повреждение ногтевых пластин;
- кандидоз слизистых оболочек рта;
- молочница органов пищеварения.


Опыт других людей
Кандидоз – распространенное заболевание, вызванное грибком Candida. У женщин проявляется в виде зуда, жжения и выделений из влагалища. У мужчин поражает кожу полового члена, вызывая зуд и покраснение. У детей кандидоз чаще всего поражает ротовую полость, вызывая молочницу. Лечение у женщин и мужчин включает применение противогрибковых мазей и препаратов, у детей – гель для рта. Важно обратиться к врачу при первых симптомах, чтобы избежать осложнений. Помимо лечения, важно поддерживать гигиену, избегать сахара и укреплять иммунитет.
Признаки молочницы
Чаще встречается кандидоз слизистых оболочек и кожи. Висцеральный тип заболевания характерен для людей с иммунодефицитными состояниями. Болезнь развивается остро: появляются зуд, жжение. На коже видны участки гиперемии с белым налетом, при поражении слизистой влагалища у женщин появляются творожистые выделения с характерным рыбным запахом.
Выраженность симптомов зависит от места локализации колонии грибков.
Без правильного лечения болезнь переходит в хроническую стадию, в тяжелых случаях развивается сепсис.
Симптомы и лечение кандидоза устанавливаются сразу для обоих партнеров. Такой подход помогает предотвратить повторное заражение.
Поражение кожи
Увидеть характерные признаки молочницы можно на фото людей, больных кандидомикозом. В зависимости от локализации очага инфицирования, болезнь подразделяется на такие группы:
- Кандидоз складок кожи.У мужчин чаще страдают межъягодичная и мошоночная зоны, у женщин – молочные железы, подмышечные впадины. На начальном этапе болезни в складках появляются пузырьки, позднее – эрозии. Они разрастаются, сливаясь между собой. Кожа приобретает темно-красный оттенок, иногда с синим отливом.
- Молочница гладкой части кожных покровов.Характеризуется эритематозными высыпаниями ярко-красного цвета. Со временем пятна покрываются ороговевшей кожей, при соскабливании которой появляются мокнущие эрозии. У взрослых кандидозные пятна локализуются на местах, где часто прикладываются повязки и компрессы.
- Поражение волосистой части головы. Внешне похоже на себорейный дерматит. Кожа покрывается мелкими белыми чешуйками. В запущенных случаях на голове появляются фурункулы, но корень волоса не повреждается.

Вагинальный кандидоз у женщин
Встречается у 75% женщин, но при сильном иммунитете протекает бессимптомно. Острый вагинальный кандидоз характеризуется такими проявлениями:
- сильным зудом;
- белыми творожистыми, неприятно пахнущими выделениями из влагалища;
- жжением при мочеиспускании;
- болезненностью полового акта;
- отеком, гиперемией (покраснением) слизистой влагалища и наружных половых органов;
Дискомфорт в паховой зоне при хронической форме молочницы усиливается перед началом менструации. В другие периоды цикла симптомы затихают.
Без лечения молочница на половых губах приводит к циститу, уретриту. Нередко дрожжеподобные грибы поражают вульву, шейку и полость матки.
Молочница у мужчин
Генитальный кандидоз проявляется в форме постита (воспаления листков крайней плоти), баланита (поражения головки пениса) или в их сочетании. Грибок на члене вызывает сыпь в области паха. Красные пятна покрыты чешуйками, иногда на головке и яичках возникают мелкие пузырьки с прозрачным содержимым.
К другим симптомам кандидозной инфекции у мужчин относятся такие проявления:
- нестерпимый зуд;
- жжение при мочеиспускании;
- покраснение и отечность крайней плоти;
- увеличение и уплотнение лимфатических узлов;
- боль при половом акте;
- появление белого налета на коже и головке пениса;
- воспаление крайней плоти.
Статьи по теме
- Противогрибковые препараты широкого спектра действия в таблетках – обзор лучших для детей и взрослых
- Грибок в горле – признаки и проявления, проведение анализа, препараты и народные средства терапии
- Грибковые заболевания у человека
Реже у мужчин встречается поражение грибками Кандида уретры и мочеиспускательного канала. Инкубационный период длится от 2 недель до 2 месяцев. Затем появляются такие симптомы:
- легкий зуд и жжение в уретре;
- скудные водянистые выделения с белесыми вкраплениями;
- режущая боль;
- неприятный запах.
Кандидоз слизистой оболочка рта
При локализации грибков в ротовой полости возможно развитие кандидозного стоматита. Болезнь характеризуется такими симптомами:
- отеком десен, языка;
- небольшими очагами покраснения;
- белым налетом на нёбе, носоглотке;
- ранками и язвами на внутренней стороне губ, щеках.
В тяжелых случаях грибковое заболевание сопровождается фарингитом, ангиной. Параллельно с кандидозным инфицированием полости рта возможен хейлит – поражение губ. Они становятся отечными, сухими, покрываются корочками. В уголках рта образуются заеды.
Кандидоз желудка
Микотические поражения ЖКТ (желудочно-кишечного тракта) встречаются редко. Заболевания характеризуются такими симптомами:
- повышением температуры тела до 38–39° С;
- болью в животе;
- ночной потливостью;
- появлением неприятного привкуса во рту;
- усталостью;
- отсутствием аппетита;
- изжогой;
- поносом или запором;
- метеоризмом кишечника;
- покалыванием и онемением конечностей.
Межпальцевая молочница
Чаще появляется на ногах между 3 и 4 пальцами. Патология сопровождается такими симптомами:
- покраснением кожной складки между пальцами;
- появлением пузырьков с прозрачной жидкостью;
- воспалением и покраснением ногтевых валиков;
- четким ограничением здоровой кожи от очага инфекции;
- зудом межпальцевого пространства;
- дискомфортом при движениях рукой или ногой.
Кандидоз у детей
Из-за несовершенства иммунной системы маленькие дети чаще взрослых подвержены кандидозному инфицированию.
Грибковое поражение кожи у малышей грудного возраста сопровождается постоянным плачем, нарушением сна, тревожностью, лихорадкой.
Из-за тонкости и повышенной чувствительности кожных покровов на теле ребенка сразу появляются изъязвления, мокнущие экземы.
Если кожный кандидоз есть у матери, грибки попадают в организм ребенка при кормлении. На щеках и внутренней стороне губ появляются белесый налет, ранки и трещины. Ребенок отказывается от еды, становится раздражительным и плаксивым. Без лечения грибки проникают в полость желудка и кишечника и вызывают такие симптомы:
- диарею;
- рвоту;
- нарушение глотания;
- общую слабость;
- боль в животе;
- колики;
- неприятный запах изо рта.
Последствия
Тяжелые осложнения молочницы появляются редко и зависят от степени снижения иммунитета, наличия сопутствующих заболеваний. Без лечения возможны такие последствия:
- железодефицитная анемия;
- геморрой;
- поражение печени, почек;
- воспаление простаты;
- эрозия шейки матки;
- кандидозный цистит, уретрит;
- сальпингит – воспаление маточных труб;
- язвенный энтерит или колит — поражение кишечника;
- бесплодие;
- фимоз – сужение крайней плоти пениса.
Особую опасность молочница представляет для беременных женщин:
- Частые рецидивы заболевания приводят к разрыхлению слизистой, что провоцирует разрывы при родах, вагинит либо эндометрит (воспаление влагалища или эндометрия тела матки) в послеродовом периоде.
- Висцеральный кандидоз опасен поражением внутренних органов у плода.
- Молочница может передаваться от матери к ребенку при прохождении его через родовые пути.
Диагностика
При появлении любых симптомов обратитесь к гинекологу, урологу или дерматологу. Во время осмотра врач выявляет воспаление, сыпь, белый налет на слизистых оболочках. Для подтверждения диагноза назначаются такие лабораторные анализы:
- ДНК-диагностика(ПЦР – полимеразная цепная реакция). Для исследования берется мазок с поверхности слизистой влагалища у женщин или уретры – у мужчин. При поверхностных формах заболевания делается соскоб с кожи или ногтя. Материал рассматривается под микроскопом. Если Кандида не обнаруживаются, выдается отрицательный результат.
- Тест FUNGIFAST AFG. Определяет чувствительность микроорганизмов к флюороцитозину и другим действующим веществам антимикотиков. Анализ назначается для исключения резистентных микроорганизмов при повторном лечении.
- Иммуноферментный анализ крови. Выявляет антитела igg к возбудителю молочницы. Положительным считается результат при титре больше 1.
Как лечить молочницу
Поверхностные тяжелые формы микозов лечатся в кожно-венерологическом диспансере, вульвовагинит – в отделении гинекологии, а заболевания мужской половой сферы – у уролога. Схема терапии подбирается в зависимости от стадии и разновидности заболевания:
- Легкая поверхностная форма кандидоза устраняется применением местных средств – противогрибковых гелей, мазей, суппозиториев. Они не всасываются в кровоток и уничтожают локальные очаги инфекции. К популярным препаратам относятся Клотримазол, Пимафуцин.
- Лечение висцеральной формы проводится с помощью системных антимикотиков. Такой подход предотвращает развитие сепсиса и других опасных осложнений. Пациентам назначаются Флуконазол, Итраконазол.
Дополнительно врач дает рекомендации по питанию. Пациентам с молочницей нужно исключить из рациона такие продукты:
- сладости;
- дрожжевую выпечку;
- хлеб;
- копчености;
- уксус;
- маринованные овощи;
- острые специи;
- жирные блюда;
- фаст-фуд;
- пиво, квас.
Лекарства при кандидозе
Основу лечения составляют противогрибковые средства в виде таблеток, свечей, мазей. Они подавляют активный рост Кандида, устраняют неприятные симптомы. Кроме антимикотиков, назначаются и специальные пробиотики.
Как правило, терапию молочницы проводят в два этапа. На первом уничтожается патогенная микрофлора, а на втором восстанавливается интимная микрофлора и местный иммунитет специальными пробиотиками (например препаратом Лактожиналь).
Препараты системного действия
Они действуют медленнее, чем местные средства, но помогают добиться стойкого терапевтического эффекта. На практике используются такие медикаменты:
- Нистатин. Нарушает обмен веществ внутри патогенной клетки, приводит к ее гибели. Резистентность микроорганизмов к лекарству развивается медленно. Нистатин используется для лечения и профилактики молочницы. При приеме возможны побочные реакции: тошнота, озноб, боль в животе.
- Флуконазол. Увеличивает проницаемость оболочки споры, нарушает ее рост и деление. Препарат назначается при генерализованных кандидозах и глубоких микозах. Флуконазол противопоказан детям до 4 лет, с осторожностью используется при тяжелых болезнях печени или почек. Во время приема возможно появление тошноты, диареи, кожной сыпи.
- Кетоконазол. Изменяет липидный состав грибков, способствует приостановлению роста и размножения микроорганизмов. Таблетки не назначаются беременным и кормящим женщинам, людям с аллергией на кетоконазол. Во время лечения возможны головные боли, сонливость, запор.
Лекарства для местного лечения
Такие медикаменты оказывают быстрое терапевтическое действие, уменьшают нагрузку на желудок, печень и почки. Местные препараты наносятся на кожу (мази, гели), вводятся внутрь влагалища либо прямой кишки (свечи). Для лечения кандидоза используются:
- Пимафуцин– вагинальные суппозитории. Нарушает целостность клеточных мембран, приводит к гибели грибка. Свечи используются при молочнице у женщин. Они противопоказаны при непереносимости натамицина. Во время лечения возможны тошнота, диарея, легкое раздражение слизистой влагалища.
- Нистатин (мазь). Обладает тем же механизмом действия, что таблетки. Мазь используется при кандидозе кожи и слизистых оболочек. Она наносится тонким слоем на пораженный участок 1–2 раза в сутки. Препарат противопоказан при непереносимости нистатина. При длительном использовании возможны понос, рвота, озноб.
- Раствор Люголя с глицерином. Обладает противомикробным действием, прижигает ранки и язвочки. Используется для лечения кандидозного стоматита у детей и взрослых. Раствором обрабатываются пораженные участки до 2 раз в сутки. Препарат противопоказан при повышенной чувствительности к йоду. Иногда вызывает раздражение слизистой и кожи, отек Квинке, насморк.
Народные средства
Дополняют основную схему лечения отвары, настои и мази из трав. Используйте их только после консультации с врачом. При кандидозе помогают такие рецепты:
- Смешайте по 30 г цветущих верхушек болиголова, листьев грецкого ореха и корня чемерицы. Залейте сырье 150 мл воды, проварите 30–40 минут. На паровой бане растопите 200 г свиного жира, добавьте 100 мл отвара. Охладите и используйте при поверхностном кандидозе 2–3 раза в день.
- Залейте 3 ст. ложки сушеных цветков календулы 500 мл кипятка. Накройте махровым полотенцем, настаивайте 40 минут. Используйте настой для обмывания половых органов 2 раза в день.
- Залейте 300 мл кипятка 15 г можжевельника. Настаивайте 3 часа. Принимайте при кандидозе желудка по 1 ст. ложке 3 раза в день. Курс лечения – 2 недели.
Профилактика
Для предотвращения нарушения микрофлоры врачи рекомендуют употреблять в пищу больше кисломолочных продуктов и овощей с противомикробным действием – чеснока, брусники, грейпфрута. Чтобы избежать развития кандидоза, придерживайтесь таких правил:
- избегайте случайных половых связей;
- носите белье из хлопчатобумажных тканей;
- после курса антибиотикотерапии принимайте пробиотики;
- соблюдайте правила личной гигиены;
- своевременно лечите болезни, проходите профилактические осмотры.
Видео
https://youtube.com/watch?v=SfOqJGV3KmQ
Внимание!
Информация, представленная в статье, носит ознакомительный характер. Материалы статьи не призывают к самостоятельному лечению. Только квалифицированный врач может поставить диагноз и дать рекомендации по лечению, исходя из индивидуальных особенностей конкретного пациента.
Статья обновлена: 22.07.2020
Частые вопросы
Как понять что у парня кандидоз?
Симптомы молочницы у мужчин зуд в области головки полового члена, жжение и отек головки полового члена и крайней плоти (кандидозный баланит, баланопостит). Кандидозный баланопостит часто сопровождается повышением полового желания из-за постоянного раздражения нервных окончаний на головке полового члена.
Как понять что у ребенка кандида?
Беловатый налет в ротовой полости.Покраснение слизистой оболочки в ротовой полости.Отказ от еды.Капризы ребенка.
Какие признаки кандидоза у женщин?
Вагинальный кандидоз («молочница») характеризуется обильными или умеренными творожистыми, сметанообразными выделениями из половых путей, иногда крошковатыми налетами на стенках влагалища или на наружных половых органах. Сопровождается такими симптомами, как зуд, жжение, раздражение в области наружных половых органов.
Как выглядит молочница у детей на гениталиях?
кремообразные или жидкие выделения из влагалища белесого, «молочного» оттенка, имеющие характерный кислый, творожистый запах, отечность, краснота кожи на половых губах и слизистых оболочках преддверия влагалища.
Полезные советы
СОВЕТ №1
При появлении симптомов кандидоза, обратитесь к врачу для точного диагноза и назначения соответствующего лечения.
СОВЕТ №2
При лечении кандидоза придерживайтесь рекомендаций врача и не прерывайте курс лечения досрочно, даже если симптомы кажутся улучшившимися.
СОВЕТ №3
Для профилактики кандидоза следите за гигиеной, избегайте длительного применения антибиотиков без назначения врача и поддерживайте иммунитет здоровым.








